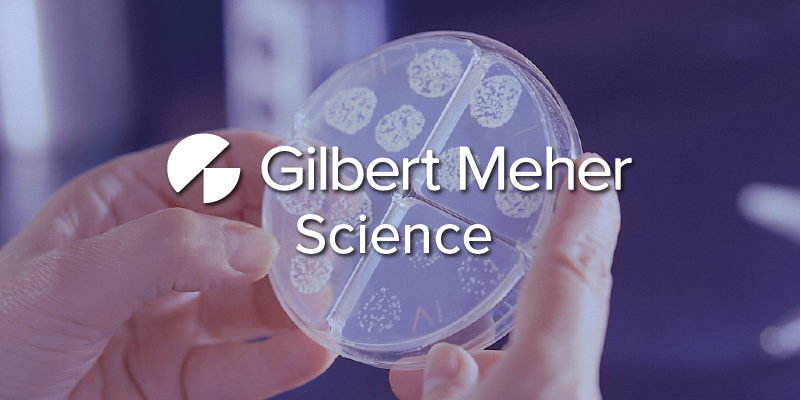

Gilbert Meher is excited to announce the launch of our new Gilbert Meher | Science page on LinkedIn.
This is the first sector-specific page we have launched, and we are proud to be dedicating it to Life Sciences. This new page will act as a hub for the entire Life Sciences sector. This will include regular news bulletins, updates on new technologies, and the latest job vacancies in the sector.
We will also be posting culture spotlights and “what they say” testimonials, where we will explore what it’s like working with our Life Sciences team. The Gilbert Meher | Science page will recognise and reward the hard work of all talented people in the Science sector, while demonstrating how we can help make an impact in the area as a first-class recruitment consultancy.
Here’s what our head of Life Sciences, Emily Legood had to say:
“As a recruiter in the Life Sciences industry, I have so many interesting conversations with market leading professionals every day. We are creating a network of exceptionally talented individuals. Why should we be the only ones to benefit from these networks and conversations? I’m passionate about creating a hub where we can celebrate technology and market wins, but also challenge areas that need improvement.”
Our upcoming segment, we will soon be launching our Women in Leadership series with a twist, so keep an eye out for exclusive interviews, controversial perspectives and insights into innovative new developments tackling the issue.